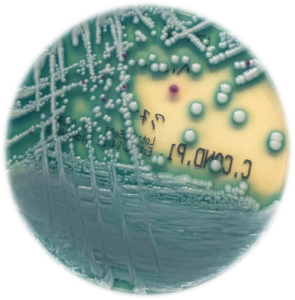
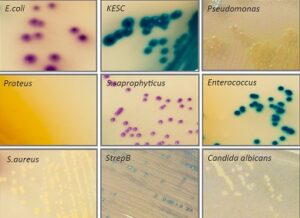

BIOCHROM LACTOBACILLUS AGAR
Το BIOCHROM LACTOBACILLUS AGAR είναι ένα χρωμογόνο τρυβλίο που χρησιμοποιείται...
CHROMagar™ CANDIDA Plus
Το CHROMagar™ Candida Plus είναι το πρώτο χρωμογόνο μέσο απομόνωσης...
Virus Transport Medium (GLYE)
Το Virus Transport Medium (GLYE) χρησιμοποιείται ως συντηρητικό υλικό για...
CHROMagar Pseudomonas
Το διχοτομημένο τρυβλίο CHROMagar™ PSEUDOMONAS – CHROMagar™ S. aureus για...
CHROMagar STREP A
Το CHROMagar™ Strep Α χρησιμοποιείται για τη Ταυτοποίηση Στρεπτόκοκκων της...
CHROMagar PSEUDOMONAS / CHROMagar S. aureus
Το διχοτομημένο τρυβλίο CHROMagar™ PSEUDOMONAS – CHROMagar™ S. aureus για...
CHROMagar ORIENTATION – MAC CONKEY AGAR
Το διχοτομημένο τρυβλίο CHROMagar™ ORIENTATION – MAC CONKEY AGAR χρησιμοποιείται...